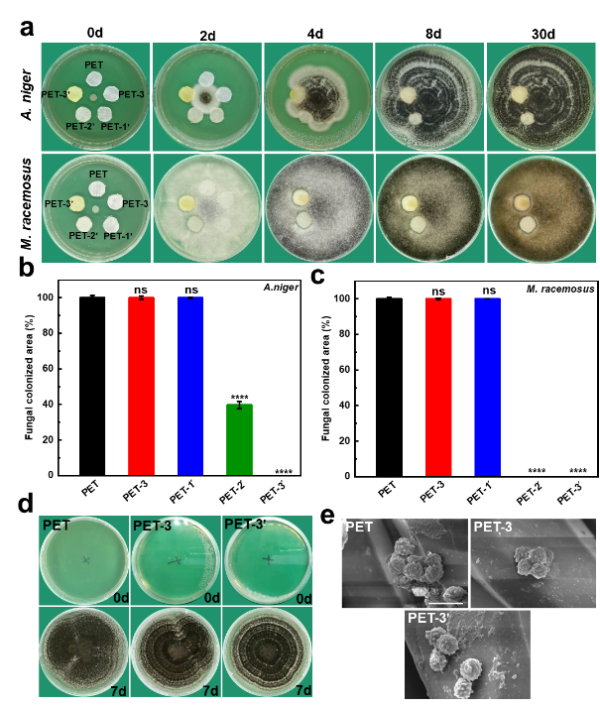

PET织物广泛用于服装、食品包装和医疗材料等领域。然而,PET织物易受环境微生物的污染,特别是真菌污染容易对织物造成不可逆的损伤,导致产品污染或功能丧失,进而威胁人们的身体健康。因此,赋予PET织物抗菌能力是非常重要的。
为此,北京化工大学生命科学与技术学院王兴教授课题组提出了一种基于立体化学与阳离子二元协同的整理方法(图1),利用阳离子聚合物(PEI)氨解PET,之后与立体化学结构单元(BF)通过席夫碱反应制备得到抗菌织物BF-PEI-PET。通过调节PEI分子量进而调控BF的修饰密度,获得了“抗粘-杀菌-安全”相统一的二元协同抗菌表面,解决了PEI修饰材料杀细菌但毒性高、对真菌/霉菌防污效果差的问题。BF-PEI二元协同形成了一个“攻防一体”的抗菌系统,满足抗菌织物既抗菌又安全的改性需求。获得的抗菌织物在食品包装和伤口敷料等方面具有很好的应用前景。

图1. 立体化学-阳离子“攻防一体”抗菌PET织物
文章要点:
(1)抗菌织物BF-PEI-PET的制备与表征。首先在碱催化条件下,PEI通过氨解反应接枝到PET织物表面;随后,表面氨基和BF醛基通过席夫碱反应共价结合,制备得到抗菌织物BF-PEI-PET(图2)。研究表明,不同分子量的PEI影响后续BF的接枝密度(相关表征见文中Fig. 1)。

图2. 抗菌PET织物的制备过程
(2)抗菌PET织物的杀菌性能(图3)。研究表明,PEI分子量的大小和PEI-PET织物的杀菌性能呈正相关。其中优选的PET-3对大肠杆菌和金黄色葡萄球菌的杀菌效率达到97.5%和99.9%。接枝BF后,织物的杀菌效率有不同程度的下降,但是织物PET-3''对大肠杆菌和金黄色葡萄球菌的杀菌效率分别保持在93.5%和99.1%,与织物PET-3没有显示出统计学差异(p>0.05)。SEM表征结果显示:接触杀伤是PET-3''织物发挥抗菌功能的主要方式。

图3. 抗菌PET织物的杀菌活性研究
(3)抗菌PET织物的抗细菌粘附性能(图4)。研究表明,PEI-PET织物的抗粘附性能和PEI的分子量相关,其中PET-3对大肠杆菌和金黄色葡萄球菌的抗粘附效率分别达到89.3%和94.3%。在BF接枝之后,PET织物都表现出更高的抗粘附效率,其中PET-3''对大肠杆菌和金黄色葡萄球菌的抗粘附效率分别达到95.1%和99.3%。SEM结果表明,PET-3''织物表面几乎没有粘附的细菌。因此,PEI和BF的结合赋予了PET织物良好的抗细菌粘附性能。

图4. 抗菌PET织物的抗细菌粘附性能研究
(4)抗菌PET织物的抗真菌粘附性能(图5)。研究表明,在第30天PET和PEI-PET织物被黑曲霉菌或总状毛霉完全覆盖,而PET-3''织物表面仍保持干净。主动接触实验(图5a-c)说明,BF的引入赋予了织物良好的抗真菌污染性能。结合被动接触实验(图5d,e),表明PET-3''织物仅对真菌孢子起抑制作用。

图5. 抗菌PET织物的抗真菌粘附性能研究
(5)抗菌PET织物的细胞毒性(图6)。研究表明,与PET-3织物组相比,PET-3''织物组的细胞存活率有明显增加,这表明BF的引入降低了PEI修饰带来的细胞毒性。荧光显微镜图像显示,PET-3织物组的死亡细胞(红色)明显多于PET-3''织物组;此外,PET-3''织物组的细胞显示出正常的梭型形态,与PET-3织物组细胞的球形形态明显不同。因此,PET-3''织物具有较低的细胞毒性。

图6. 抗菌PET织物的细胞毒性研究
(6)抗菌织物PET-3''的应用研究。
食品贮藏:以织物作为封口材料,对水和牛奶介质的保质实验(图7)表明,存放48小时后,PET-3''织物组的细菌菌落数显著低于PET组,存在统计学差异。这一现象表明,PET-3''织物能够有效阻止环境微生物进入容器中,从而延长食品的保质期。因此,抗菌织物PET-3''在食品包装领域具有潜在的应用价值。

图7. 抗菌织物PET-3''在食品包装中的应用研究
伤口敷料:以织物作为伤口敷料,对金黄色葡萄球菌感染伤口进行包扎处理(图8),结果显示,PET-3''织物组的小鼠伤口愈合速率显著高于PET织物组(p<0.05),表明抗菌织物PET-3''对感染伤口有潜在的治疗作用。

图8. 抗菌织物PET-3''作为伤口敷料的应用研究
此外,本文还对抗菌PET织物的机械性能和洗涤耐久性进行了研究。结果表明,抗菌PET织物具有良好的机械性能和洗涤耐久性(相关结果见文中Fig. 8)。
综上所述,本文利用立体化学与阳离子二元协同的整理方法制备了抗菌PET织物。获得的抗菌织物具有较高的杀菌效率、良好的抗菌粘附性能和较低的细胞毒性。该织物在食品贮藏和促进伤口愈合方面具有应用潜力。立体化学和阳离子之间的二元协同被证明是一种可行的“攻防一体”抗菌策略。可以乐观地预期,立体化学抗菌策略与其他传统抗菌策略的结合也将取得双赢效果。
相关研究成果近期以“Dual Coordination between Stereochemistry and Cations Endows Polyethylene Terephthalate Fabrics with Diversiform Antimicrobial Abilities for Attack and Defense”为标题发表在ACS Applied Materials & Interfaces杂志上 (IF = 10.383)。本论文第一作者为北京化工大学生命科学与技术学院博士研究生张鹏飞,北京化工大学王兴教授为论文的通讯作者。该研究工作得到国家自然科学基金的资助与支持。
本工作是立体化学抗菌策略的最新研究进展之一。立体化学抗菌策略是利用微生物对材料的手性偏好而发展的攻/防策略,一方面避免菌耐药,一方面克服耐药菌,从两个方面共同应对微生物耐药这一生物安全问题。在避免菌耐药方面,立足于管控微生物行为,利用微生物感知不同立体化学结构并做出不同响应的特点,从而使微生物不主动粘附到材料表面,有效抑制有害微生物的粘附、繁殖和传播,符合抗菌材料发展的新趋势。成果包括ACS Applied Materials & Interfaces 2014, 6, 19371;ACS Applied Materials & Interfaces 2016, 8, 28522;Advanced Healthcare Materials 2019, 8, 1900232;Carbohydrate Polymers 2020, 228, 115378;Journal of Materials Science & Technology 2021, 69, 79等;此外,在PET抗菌改性方面的基础研究包括ACS Applied Polymer Materials 2021, 3, 3702;Colloid and Interface Science Communications 2022, 46, 100567;ACS Biomaterials Science & Engineer 2022, 8, 570;ACS Applied Polymer Materials 2022, 4, 1922。立体化学抗菌粘附的优势在于:对细菌、真菌/霉菌等广谱微生物具有普适性;表面抑菌粘附但不杀菌,对皮肤菌群友好;疏水性抗菌高分子与传统亲水性抗菌高分子互为补充、协同双赢;解决了传统抗菌材料抗菌谱窄或毒性偏高等问题。另外,在克服耐药菌方面,课题组基于立体化学抗菌策略,发展了具有微生物亲和性的手性聚氨基酸等高分子药物递送系统,针对胞内耐药菌、瘤内耐药菌和膜内耐药菌等开展了突破细菌耐药屏障方面的基础研究工作,成果包括Advanced Materials 2022, 34, 2109789; Advanced Materials 2022, 34, 2206765; Advanced Science 2022, 9, 2200732等。
文章链接:https://pubs.acs.org/doi/10.1021/acsami.2c19323